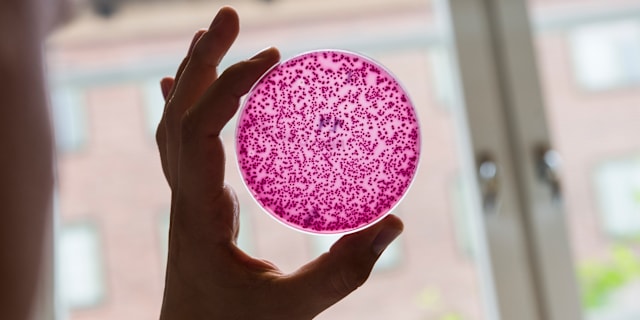

Culture plate with bacteria. Illustration image. Lars Pehrson / SvD / TT
The development of AI
"Breakthrough shows that AI can save us - not just kill"
That researchers this week discovered with the help of AI that a new type of antibiotic can defeat the deadly bacterium Acinetobacter baumannii is an important reminder that technology can save us - not just kill us. That's what The Independent's Andrew Griffin writes in a column.
Griffin notes that over the past year, AI has been surrounded by alarms about the enormous danger the technology could pose to humanity. The important breakthroughs have received less attention.
"The news is a welcome reminder that not all positivity is exaggerated. Just like bacteria, AI can both help and harm us.”

Archive image. Lab tests. Elaine Thompson/AP
AI behind breakthrough in the fight against killer bacteria
Using artificial intelligence, American researchers have discovered a new type of antibiotic that can kill the deadly and multi-resistant bacterium Acinetobacter baumannii, reports the BBC.
The bacterium is classified as a "critical threat" to human health by the World Health Organization. According to the WHO, the bacterium has an ability to find new ways to resist treatment and can also pass on these lessons to other bacteria. It poses a particularly great threat to people with a weakened immune system and can, among other things, infect wounds and cause pneumonia.
The BBC calls the study, published in the journal Nature, the latest example of how AI can become a revolutionary force in science and medicine.
Inga kommentarer:
Skicka en kommentar